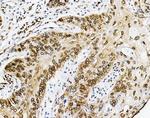
Emerin Antibody in Immunohistochemistry (Paraffin) (IHC (P))

Search
Invitrogen
Emerin Polyclonal Antibody
{{$productOrderCtrl.translations['antibody.pdp.commerceCard.promotion.promotions']}}
{{$productOrderCtrl.translations['antibody.pdp.commerceCard.promotion.viewpromo']}}
{{$productOrderCtrl.translations['antibody.pdp.commerceCard.promotion.promocode']}}: {{promo.promoCode}} {{promo.promoTitle}} {{promo.promoDescription}}. {{$productOrderCtrl.translations['antibody.pdp.commerceCard.promotion.learnmore']}}
图: 1 / 14
Emerin Antibody (PA5-79201) in ICC/IF

Please note: We are reviewing Western blot images included in the antibody testing data in our catalog, including those provided by third parties. Unless expressly labeled or annotated as “raw-unedited”, Western blot images included in the antibody testing data in our catalog may have been edited, optimized or otherwise adjusted for presentation.
产品信息
PA5-79201
种属反应
宿主/亚型
分类
类型
抗原
偶联物
形式
浓度
规格
纯化类型
保存液
内含物
保存条件
运输条件
RRID
产品详细信息
Reconstitute with 0.2 mL of distilled water to yield a concentration of 500 µg/mL.
Positive Control - WB: human Hela whole cell, human 293T whole cell, rat NRK whole cell, rat C6 whole cell, mouse NIH/3T3 whole cell, mouse Neuro-2a whole cell. IHC: human endometrial carcinoma tissue, human colon cancer tissue, human oesophagus squama cancer tissue. ICC/IF: U20S cell. Flow: U20S cell.
靶标信息
Xeroderma pigmentosum type G (XPG) is a human genetic disease exhibiting extreme sensitivity to sunlight. The XPG protein, a member of the flap endonuclease 1 (FEN-1) structure-specific DNA repair endonuclease family, is an enzyme essential for DNA repair of the major kinds of solar ultraviolet (UV)-induced DNA damages. Human XPG nuclease makes the 3' incision during nucleotide excision repair of DNA. The enzyme cleaves model DNA bubble structures specifically near the junction of unpaired DNA with a duplex region. A 29-amino acid region of human XPG (residues 981-1009) contains the PCNA binding activity. A conserved arginine in XPG (Arg992) is crucial for its PCNA binding activity. Replication Protein A (RPA) binds specifically and directly to two excision repair proteins, the xeroderma pigmentosum damage-recognition protein XPA and the endonuclease XPG.
仅用于科研。不用于诊断过程。未经明确授权不得转售。
篇参考文献 (0)
生物信息学
蛋白别名: Emerin
基因别名: AW550900; EDMD; EMD; STA
UniProt ID: (Mouse) O08579, (Rat) Q63190
Entrez Gene ID: (Mouse) 13726, (Rat) 25437




